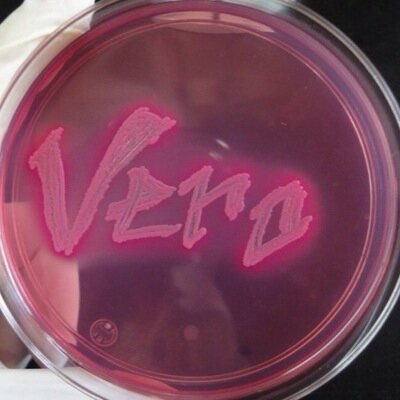

jose arturo cuessi @JOSECUESSI
Joined October 2011-
Tweets9
-
Followers20
-
Following42
-
Likes0
Trends for United States
1.741 posts
1.036 posts
14,9 B posts
61 B posts
4.809 posts
3.061 posts
42,6 B posts
7.870 posts
5.373 posts
16,7 B posts
13,4 B posts
26,7 B posts
10,1 B posts
12,4 B posts
9.544 posts
4.616 posts
11,7 B posts
5.793 posts